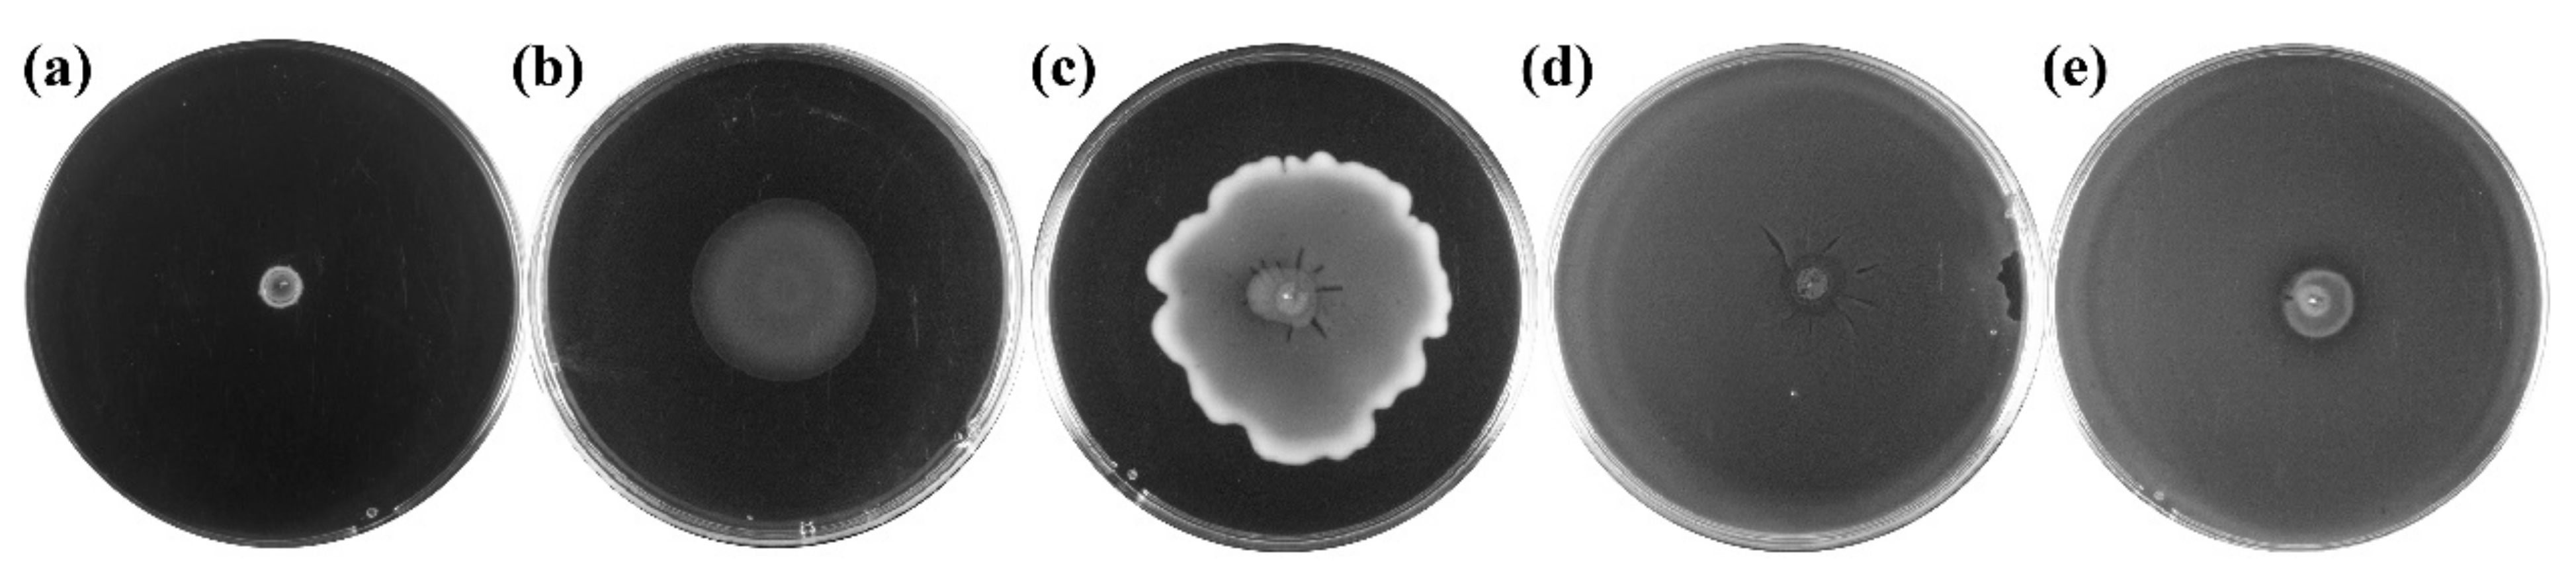
Foods 11 03639 g002 Foods 11 03639 g002

Chemotaxis of Clostridium Strains Isolated from Pit Mud and Its Application in Baijiu Fermentation
Abstract
1. Introduction
2. Materials and Methods
2.1. Collection of Samples
2.2. Isolation and Cultivation of Clostridium
2.3. Identification of Bacteria
2.4. Analysis of Clostridium Motility
2.5. Analysis of Chemotaxis of Clostridium
2.6. Examination of Chemotaxis and Migration of Clostridium in Pit Mud
2.7. Migration and Metabolism of Clostridium in a Simulated Baijiu Fermentation System
2.8. Analysis of Organic Acids
2.9. Construction of Phylogenetic Tree
2.10. Statistical Analysis
3. Results
3.1. Isolation of Clostridium Strains from Pit Mud and Determination of Their Motility
3.2. Chemotaxis of Clostridium
3.3. Migration of Clostridium within the Pit Mud
3.4. Reduction of Lactic Acid Content in Fermented Grains by Clostridium through Chemotaxis
4. Discussion
Author Contributions
Funding
Data Availability Statement
Conflicts of Interest
Appendix A
| Represent Strain | Species | Similarity (%) | Reference Sequence ID |
|---|---|---|---|
| W12 | Clostridium amylolyticum | 99 | NR_044386.1 |
| W10 | Clostridium beijerinckii | 99 | MN733990.1 |
| W3 | Clostridium butyricum | 99 | MT510294.1 |
| W8 | Clostridium cochleatum | 99 | LT906477.1 |
| W4 | Clostridium intestinale | 96 | MT000030.1 |
| W5 | Clostridium kogasensis | 100 | NR_136452.1 |
| W9 | Clostridium pabulibutyricum | 98 | NR_159224.1 |
| W13 | Clostridium saccharoperbutylacetonicum | 99 | CP016087.1 |
| W14 | Clostridium sartagoforme | 98 | MN646980.1 |
| W7 | Clostridium sp. | 99 | AF443594.1 |
| W2 | Clostridium sphenoides | 100 | LT630003.1 |
| W11 | Clostridium subterminale | 98 | MG543819.1 |
| W6 | Clostridium tertium | 99 | MT539086.1 |
| W1 | Clostridium tyrobutyricum | 98 | MT269011.1 |
| Species | Number of Strains | Motile (%) |
|---|---|---|
| Clostridium amylolyticum | 4 | 100 |
| Clostridium beijerinckii | 4 | 100 |
| Clostridium butyricum | 17 | 82.4 |
| Clostridium celerecresens | 12 | 100 |
| Clostridium cochleatum | 1 | 100 |
| Clostridium intestinale | 1 | 100 |
| Clostridium kogasensis | 2 | 100 |
| Clostridium pabulibutyricum | 2 | 100 |
| Clostridium saccharoperbutylacetonicum | 1 | 100 |
| Clostridium sartagoforme | 5 | 100 |
| Clostridium sp. | 24 | 83.3 |
| Clostridium sphenoides | 1 | 100 |
| Clostridium subterminale | 1 | 100 |
| Clostridium tertium | 30 | 60 |
| Clostridium tyrobutyricum | 5 | 60 |
References
- Lin, L.H.; Guo, S.B. Effect of fermentation processing on the flavor of baijiu. J. Agric. Food Chem. 2018, 66, 5425–5432. [Google Scholar]
- Liu, X.; Guo, K.L.; Zhang, H.X. Determination of microbial diversity in Daqu, a fermentation starter culture of Maotai liquor, using nested PCR-denaturing gradient gel electrophoresis. World J. Microb. Biot. 2012, 28, 2375–2381. [Google Scholar]
- Wei, Z.; Ye, G.B.; Zhang, K.Z. Diversity, function, and application of Clostridium in Chinese strong flavor baijiu ecosystem: A review. J. Food Sci. 2018, 83, 1193–1199. [Google Scholar]
- Fang, G.Y.; Chai, L.J.; Zhong, X.Z.; Lu, Z.M.; Zhang, X.J.; Wu, L.H.; Wang, S.T.; Shen, C.H.; Shi, J.S.; Xu, Z.H. Comparative genomics unveils the habitat adaptation and metabolic profiles of Clostridium in an artificial ecosystem for liquor production. mSystems 2022, 7, e00297-22. [Google Scholar] [CrossRef]
- Mattingly, A.E.; Weaver, A.A.; Dimkovikj, A.; Shrout, J.D. Assessing travel conditions: Environmental and host influences on bacterial surface motility. J. Bacteriol. 2018, 200, e00014-18. [Google Scholar] [CrossRef]
- Liu, M.K.; Tang, Y.M.; Guo, X.J.; Zhao, K.; Tian, X.H. Deep sequencing reveals high bacterial diversity and phylogenetic novelty in pit mud from Luzhou Laojiao cellars for Chinese strong-flavor Baijiu. Food Res. Int. 2017, 102, 68–76. [Google Scholar] [CrossRef]
- Tao, Y.; Li, J.B.; Rui, J.P.; Xu, Z.C.; Zhou, Y.; Hu, X.H.; Wang, X.; Liu, M.H.; Li, D.P.; Li, X.Z. Prokaryotic communities in pit mud from different-aged cellars used for the production of Chinese strong-flavored liquor. Appl. Environ. Microb. 2014, 80, 2254–2260. [Google Scholar] [CrossRef]
- Zhang, Q.Y.; Yuan, Y.J.; Luo, W.; Zeng, L.Y.; Wu, Z.Y.; Zhang, W.X. Characterization of prokaryotic community diversity in new and aged pit muds from Chinese Luzhou-flavor liquor distillery. Food Sci. Technol. Res. 2017, 23, 213–220. [Google Scholar] [CrossRef]
- Wang, X.J.; Zhu, H.M.; Ren, Z.Q.; Huang, Z.G.; Wei, C.H.; Deng, J. Characterization of microbial diversity and community structure in fermentation pit mud of different ages for production of strong-aroma baijiu. Pol. J. Microbiol. 2020, 69, 151–164. [Google Scholar] [CrossRef]
- Hu, X.L.; Tian, R.J.; Wang, K.L.; Cao, Z.H.; Yan, P.X.; Li, F.Q.; Li, X.S.; Li, S.L.; He, P.X. The prokaryotic community, physicochemical properties and flavors dynamics and their correlations in fermented grains for Chinese strong-flavor Baijiu production. Food Res. Int. 2021, 148, 110626. [Google Scholar] [CrossRef]
- Liang, H.P.; Li, W.F.; Luo, Q.C.; Liu, C.L.; Wu, Z.Y.; Zhang, W.X. Analysis of the bacterial community in aged and aging pit mud of Chinese Luzhou-flavour liquor by combined PCR-DGGE and quantitative PCR assay. J. Sci. Food Agric. 2015, 95, 2729–2735. [Google Scholar] [CrossRef] [PubMed]
- Hu, X.L.; Yu, M.; Wang, K.L.; Tian, R.J.; Yang, X.; Wang, Y.L.; Zhang, Z.G.; Zhao, X.M.; He, P.X. Diversity of microbial community and its correlation with physicochemical factors in luzhou-flavor liquor pit mud. Food Res. Dev. 2021, 42, 178–185. [Google Scholar]
- Liu, Q.; Weng, P.; Wu, Z. Quality and aroma characteristics of honey peach wines as influenced by different maturity. Int. J. Food Prop. 2019, 23, 445–458. [Google Scholar] [CrossRef]
- Zhang, M.; Wu, X.; Mu, D.; Yang, W.; Li, X. Profiling the effects of physicochemical indexes on the microbial diversity and its aroma substances in pit mud. Lett. Appl. Microbiol. 2020, 71, 667–678. [Google Scholar] [CrossRef] [PubMed]
- Wu, L.T.; Ding, W.J.; Xie, Z.; Zhang, Z.Y.; Wang, Q.T.; Zhou, F.L.; Fang, J.; Fang, F. Characterization and correlation analysis of the bacterial composition, physicochemical properties and volatiles in Baijiu fermentation pit mud of different ages. Microbiol. China 2022, 49, 18. [Google Scholar]
- Chai, L.J.; Qian, W.; Zhong, X.Z.; Zhang, X.J.; Xu, Z.H. Mining the factors driving the evolution of the pit mud microbiome under the impact of long-term production of strong-flavor baijiu. App. Environ. Microb. 2021, 87, e00885-21. [Google Scholar] [CrossRef] [PubMed]
- Wang, X.S.; Du, H.; Xu, Y. Source tracking of prokaryotic communities in fermented grain of Chinese strong-flavor liquor. Int. J. Food Microbiol. 2017, 244, 27–35. [Google Scholar] [CrossRef]
- Gao, J.J.; Liu, G.Y.; Li, A.J.; Liang, C.C.; Ren, C.; Xu, Y. Domination of pit mud microbes in the formation of diverse flavour compounds during Chinese strong aroma-type baijiu fermentation. LWT-Food Sci. Technol. 2021, 137, 110442. [Google Scholar] [CrossRef]
- Qian, W.; Lu, Z.M.; Chai, L.J.; Zhang, X.J.; Li, Q.; Wang, S.T.; Shen, C.H.; Shi, J.S.; Xu, Z.H. Cooperation within the microbial consortia of fermented grains and pit mud drives organic acid synthesis in strong-flavor Baijiu production. Food Res. Int. 2021, 147, 110449. [Google Scholar] [CrossRef]
- Wang, X.; Du, A.H.; Zhang, A.Y.; Xu, B.Y. Environmental microbiota drives microbial succession and metabolic profiles during Chinese liquor fermentation. Appl. Environ. Microb. 2018, 84, e02369-17. [Google Scholar] [CrossRef]
- Gou, W.J.; Tian, Y.; Kong, X.Y.; Wu, F.F.; Fang, F. Bacterial composition in pit mud of Yanghe liquor and identification of acid producing bacteria. Microbiol. China 2020, 47, 1651–1661. [Google Scholar]
- Parales, R.E.; Ditty, J.L. Chemotaxis to atypical chemoattractants by soil bacteria. Methods Mol. Biol. 2018, 1729, 255–280. [Google Scholar] [PubMed]
- Xu, P.X.; Chai, L.J.; Qiu, T.; Zhang, X.J.; Xu, Z.H. Clostridium fermenticellae sp. nov., isolated from the mud in a fermentation cellar for the production of the Chinese liquor, baijiu. Int. J. Syst. Evol. Microbiol. 2019, 69, 859–865. [Google Scholar] [CrossRef] [PubMed]
- Pu, X.X.; Chai, L.J.; Xu, P.X.; Zhang, X.J.; Lu, Z.M.; Wang, S.T.; Shen, C.H.; Xu, Z.H. Isolation and metabolic characters of Clostridium strains from pit mud of Luzhou-flavor baijiu. Acta Microbiol. Sin. 2019, 59, 2427–2436. [Google Scholar]
- Chai, L.J.; Xu, P.; Qian, W.; Zhang, X.J.; Ma, J.; Lu, Z.M.; Wang, S.T.; Shen, C.H.; Shi, J.S.; Xu, Z.H. Profiling the Clostridia with butyrate-producing potential in the mud of Chinese liquor fermentation cellar. Int. J. Food Microbiol. 2019, 297, 41–50. [Google Scholar] [CrossRef] [PubMed]
- Qian, W.; Lu, Z.M.; Chai, L.J.; Zhang, X.J.; Xu, P.X.; Li, Q.; Wang, S.T.; Shen, C.H.; Shi, J.S.; Xu, Z.H. Differences of the structure, succession and function of Clostridial communities between jiupei and pit mud during Luzhou-flavour baijiu fermentation. Chin. J. Biotechnol. 2020, 36, 1190–1197. [Google Scholar]
- Xiao, C.; Lu, Z.M.; Zhang, X.J.; Wang, S.T.; Li, D.L.; Shen, C.H.; Shi, J.S.; Xu, Z.H. Bacterial community succession in fermented grains of Luzhou-flavor baijiu. Acta Microbiol. Sin. 2019, 59, 195–204. [Google Scholar]
- Liu, M.; Zhao, K.; Tang, Y.; Ren, D.Q.; Yao, W.C.; Tian, X.H.; Zhang, X.Y.; Yi, B.; Deng, B. Analysis of Clostridium cluster I community diversity in pit mud used in manufacture of Chinese Luzhou-flavor liquor. J. Food Sci. Biotechnol. 2015, 24, 995–1000. [Google Scholar] [CrossRef]
- Zhang, H.M.; Wang, Y.L.; Meng, Y.J.; Wang, Y.H.; Li, A.J.; Wang, Z.Q.; Zhang, Z.Z.; Xing, X.H. Differences in physicochemical properties and prokaryotic microbial communities between young and old pit mud from Chinese strong-flavor baijiu brewing. Food Sci. 2020, 41, 207–214. [Google Scholar]
- Ji, X.; Xu, Y.; Mu, X.Q.; Ge, X.Y. Improvement of caproic acid production in the mixed culture of Clostridium kluyveri and Saccharomyces cerevisiae. J. Food Sci. Biotechnol. 2017, 36, 922–926. [Google Scholar]
- Jeong, J.H.; Kim, J.N.; Wee, Y.J.; Ryu, H.W. The statistically optimized production of poly(γ-glutamic acid) by batch fermentation of a newly isolated Bacillus subtilis RKY3. Bioresour. Technol. 2010, 101, 4533–4539. [Google Scholar] [CrossRef] [PubMed]
- Karmakar, R. State of the art of bacterial chemotaxis. J. Basic Microb. 2021, 61, 366–379. [Google Scholar] [CrossRef] [PubMed]
- Zhu, X.Y.; Shen, C.Y.; Chen, G.W.; Zhang, W.; Li, B.G.; Wang, G. Advancement in research on bacterial chemotaxis in soil. Acta Pedol. Sin. 2019, 56, 259–275. [Google Scholar]

Publisher’s Note: MDPI stays neutral with regard to jurisdictional claims in published maps and institutional affiliations. |
© 2022 by the authors. Licensee MDPI, Basel, Switzerland. This article is an open access article distributed under the terms and conditions of the Creative Commons Attribution (CC BY) license (https://creativecommons.org/licenses/by/4.0/).
Share and Cite
Wu, L.; Fan, J.; Chen, J.; Fang, F. Chemotaxis of Clostridium Strains Isolated from Pit Mud and Its Application in Baijiu Fermentation. Foods 2022, 11, 3639. https://doi.org/10.3390/foods11223639
Wu L, Fan J, Chen J, Fang F. Chemotaxis of Clostridium Strains Isolated from Pit Mud and Its Application in Baijiu Fermentation. Foods. 2022; 11(22):3639. https://doi.org/10.3390/foods11223639
Chicago/Turabian StyleWu, Langtao, Jingya Fan, Jian Chen, and Fang Fang. 2022. "Chemotaxis of Clostridium Strains Isolated from Pit Mud and Its Application in Baijiu Fermentation" Foods 11, no. 22: 3639. https://doi.org/10.3390/foods11223639
APA StyleWu, L., Fan, J., Chen, J., & Fang, F. (2022). Chemotaxis of Clostridium Strains Isolated from Pit Mud and Its Application in Baijiu Fermentation. Foods, 11(22), 3639. https://doi.org/10.3390/foods11223639

